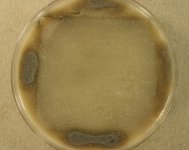

Search Details
| UAMH Number: | 9702 |
|---|---|
| Species Name: | Cornuvesica falcata |
| Type: | |
| Synonyms: | Ceratocystiopsis falcata / Ceratocystis falcata |
| Taxonomy: | FUNGI Ascomycota, Sordariomycetes, Ophiostomatales, Ophiostomataceae |
| Strain History: | Reid, J. (UM 792) -> UAMH |
| Substrate: | Monterey pine (Pinus radiata) | Location: | NEW ZEALAND Kaingaroa State Forest, Taupo, Compartment 1212 (GEO: -38.378,176.501) |
| Isolator: | J. & B. Reid (88-305) |
| Isolation Date: | 1988-02-17 |
| Date Received: | 2000-02-01 |
| Characters: | CULTURE CONDITIONS produced fertile ascomata on CERC - // CYCLOHEXIMIDE resistant - Hausner, Reid & Klassen, Mycol. Res. 97:625-633, 1993 // MOLECULAR SYSTEMATICS molecular genetic variation among members of the genus Ceratocystiopsis - Hausner, Reid & Klassen, Mycol. Res. 97:625-633, 1993 // MOLECULAR SYSTEMATICS phylogeny of Cornuvesica, Sphaeronaemella and Gabarnaudia - Hausner G, Reid J, Can J Bot 82:752-762, 2004 // MOLECULAR SYSTEMATICS relationships among Ceratocystis & Ophiostoma species based on rDNA ITS - Hausner, Reid & Klassen, Can. J. Bot. 78:903-916, 2000 // MOLECULAR SYSTEMATICS relationships between the genera Ceratocystis & Ophiostoma - Hausner, Reid & Klassen, Can. J. Bot. 71:52-63, 1993 // SYSTEMATICS/ TAXONOMY notes on Cornuvesica falcata - Hausner, Eyjolfsdottir & Reid, Can. J. Bot 81:40-48, 2003 (Click for publications citing UAMH 9702) |
| Compounds: | |
| Cross Reference: | UM 792 // WIN(M) 792 |
| Collections: | Living Strains; Dried Herbarium Material |
| Pathogenic Potential: | Human: no | Animal: no | Plant: yes |
| Biosafety Risk Group: | RG1 (check the PHAC ePATHogen Risk Group Database for updates) |
| Regulatory Requirements: | Canadian requesters must provide PHAC Pathogen and Toxin License Number (see: https://www.canada.ca/en/public-health/services/laboratory-biosafety-biosecurity/licensing-program.html) prior to shipment. International requesters must provide all legally required importation documentation prior to shipment. Plant pathogenicity status may be verified by using the USDA Agricultural Research Service (ARS) Fungal Database |
| MycoBank ID: | 464609 |
| Sequences: | >UAMH09702_FJ895609 ATTATTGATATTTAAATTGGGTTAAATTCAAGAATTACTTTTTTTTTAAGTAAATTTGAAGCGAAATTTATCTTAGCAAAATTATATAGAGATATAAACGTTCAACGACTAAAAAGTGAGTTATTGCTAACAATAATCTTTTAATTTAAACCTGACATTTTTATTTATTAAGTATTTTTAAACAACAGAAAAAAAAACACGTTTTTAGATGAAATTAAAAAATAATATCTTTTATTTTTTTTTTAATAATAAATTAAAAAAAACACATTTAAACTTAAAAAAAAGTGATTTAAGAAAAATAAAATATTTTCCAGCTTATTCTAATGAATGGAAAAATATTATTTATTATTTTAATAATAATAATTTAAAAAATGTTTCTATAGAATACTTAAATATTAATAAAATAATAAAATTTTATTTTAATTTATATTTTAAAGATAATAGTTTATTTTTAATAAATAAATTATTAGAAAAAAAATGTTTTTTTTTTAATAAAAAAAAACATTTTTTAAGAAATATCCATATTAGTCAAACTGAAATAAAACATAAAAATAATAAAATAATTATTAATTTATATATTTTAAATTTAGAAAAAAATATTTTAATAAAAAGATTTTTAATTACATTAAATAAATATAATAAAAATATATATAATAATATAAAATCTATAACTAATTTAAAAAAAAAAACATATTTATACTTATATAATATATTTAATAATAATATTATTATTAATAAAAATGTAAAAAAAAATTTTTTAAAAAAATTTATATATTCATATTTTATATTAAAAAAAATATTATTTAAAAAATTGATAATAATTAGAAAATATCAATATATTTATTTATTTAACAAATATAAATTTGATAATACTTATTTATTATATAAATTAAGTAATATTATATCTAATTTATCATTATTTAAAGCTAAATTAATAGAATTTAATATAATAAATATTAAATCTTTTGCTTATAATGCAGATATATTTACTAATGTATTATCTTTAAAATTAAAAAAAAAAAGAATCAAATTATTAAAAGGAATTAATAGTATTTTAAATAGAGCTAAATTTCCAAAAATTAATTCTTTAGTGGAAAGAGCTAATAAAATTAAATATAAAGATTCTAATTTAATGGAGAATAAATTTAAAGATACTAAATTAGTATCTTTATTAAAAGATAATTTATATCTTTTTTTATATAATAATTTATATAATGAAAGTAAATATATTAATTATAATAAAGAATTTTATAAAATATATTATAATATATTTAACTCAATACATTATAAAAATATGGGTGGAATTCGTTTAATAGTAAAAGGAAGATTAACAAAAAGATATAGAGCTGATCGTGCAATTATGAAGTTAAAGTGGAAAGGAGGATTAAAAAATGGAAGAAGCGTCTTAGGATGGGTTGTCGGAGGCGGAGTAAAGGGGTAAAAATCCTAGGAAGGGAAATTATTCTAGACGCAAAAGTAAGCGAAGAAGTGGCGCCCGGGCAGTTAAAGGACGAATTGCAGG >UAMH09702_L05963_SSU GGCTACTACATCTAAGGAAGGCAGCAGGCGCGCAAATTACCCAATCCCCACGGGGAGGTAGTGACAATAAATACTGATACAGGGCTCTTTTGGGTCTTGTAATCGGAATGAGTACAATTTAAATCCCTTAACGAGGAACCAGTGGAGGGCAAGTCTGGTGCCAGCAGCCGCGGTAATACCAGCTCCACTAGCGTATATTAAAGTTGTTGTGGTTAAAAAGCTCGTAGTTGAACCTAGTGGTCTACTGTCTTCTGTCCTCACCGATGGAAGATTGGTGGGCCACCACCGGTCGTGATGGTAACGTCACGGCCACGATTACTTTGAAAAAATTAGAGTGCTCCAGGCAGGCTTATGCTCGAATAGTTCAGCATGGAATAATAAAATAGGACGTGGGGTTCTATTTTGTTGGTTTCTAGGACCAGCGTAATGATGAATAGGGACAGTCGGGGGCATCCGT >UAMH09702_AY271797_SSU ACAGCGAAACTGCGAATGGCTCATTATATAAGTTATCGTTTATTTGATAGCACCTTACTACTTGGATAACCGTGGTAATTCTAGAGCTAATACATGCTAAAAATCCCGACTTCGGAAGGGATGTATTTATTAGATTAAAAACCAATGCCTTCGGGCTTTCTGGTGATTCATGATAACTACTCGAATCAGCATGGCCTTGCGCCGGCGATGGTTCATTCAAATTTCTTCCCTATCAACTTTCGATGCGAAGGTCTTGTCTTCGCATGGTTACAACGGGTAACGGAGGGTTAGGGCTCGACCCCGGAGAGGGAGCCTGAGAAAGGCTACCACTTTTAAGGAAGGCAGCAGGCGCGCAAATTACCCAATCCCGACACGGGGAGGTAGTGACAATAAATACTGATACAGGGCTCTTATGGGTCTTGTAATCGGAATGAGTACAATTTAAATCCCTTAACGAGGAACAATTGGAGGGCAAGTCTGGTGCCAGCAGCCGCGGTAATTCCAGCTCCAATAGCGTATATTAAAGTTGTTGTGGTTAAAAAGCTCGTAGTTGAACCTTGGGCCTGGCTGGCCGGTCCCCCTCACCGGGTGCACTGGTTCCGGCCGGGTCTTTCCCTCTGTGGAACCGCATGCCCTTCACTGGGTGTGTCGGGGAAACAGGACTTTTACTTTGAAAAAATTAGAGTGCTCCAGGCAGGCTTATGCTCGAATAGTTCAGCATGGAATAATAAAATAGGACGTGGGTTCTATTTTGTTGGTTTCTAGGACCGCCGTAATGATTAATAGGGACAGTCGGGGGCATCCGTATTCCTCAGTCAGAGGTGAAATTCTTGGATCTGAGGAAGACGAACTACTGCGAAAGCATTTGCCAAGGATGTTTTCATTAATCAGGAACGAAAGTTAAGGTCGCGAAAACGATCAGATACCGTTGTAGTCTTAACTATAAACTATGCCGACTAGGGATTGGATGCTGTCTTTACCGAACGCATCCAGCACCTTTCGAGAAATCAAAGTGCTTGGGCTCCAGGGGGAGTATGGTCGCAAGGCTGAAACTTAAAGAAATTGACGGAAGGGCACCACCAGGAGTGGAGCCTGCGGCTTAATTTGACTCAACACGGGGAAACTCACCAGGTCCAGACACAGTGAGGATTGACAGATTGAGAGCTCTTTCATGATTCTGTGGGTGGTGGTGCATGGCCGTTCTTAGTTGGTGGAGTGATTTGTCTGCTTAATTGCGATAACGAACGAGACCTTCTCCTACTAACTAGCCCGCATTGCTTTGGCAGTGTGCTGGCTTCTTAGCGGGACTCTCTATGTAAATAGAGGGAAGTGGGAGGCAATAACAGGTCTGTGATGCCCTTAGATGTTCTGGGCCGCACGCGCGCTACACTGACCAAGCCAGCGAGTTACCTTGGCTGAGAAGCCTGGGGAATCTTGGGAAACTTGGTCGTGCTGGGGATAGAGCATTGCAATTGTTGCTCTTCAACGAGGAATTCCTAGTAAGCGCAAGTCATCAGCTTGCGTTGATTACGTCCCTGCCCTTTGTACACACCGCCCGTCGCTACTACCGATTGAATGGCTCAGTGAGGCCATCGGACTGGCCTTTTTAGCGGGCAACTGCTGAGAAGGCCGGAAAGTTGTCCAAACTCGGTCATTTAGAGGAAGTAAAAGTCGTAACAAGGTTCCGTA |
IMAGES: